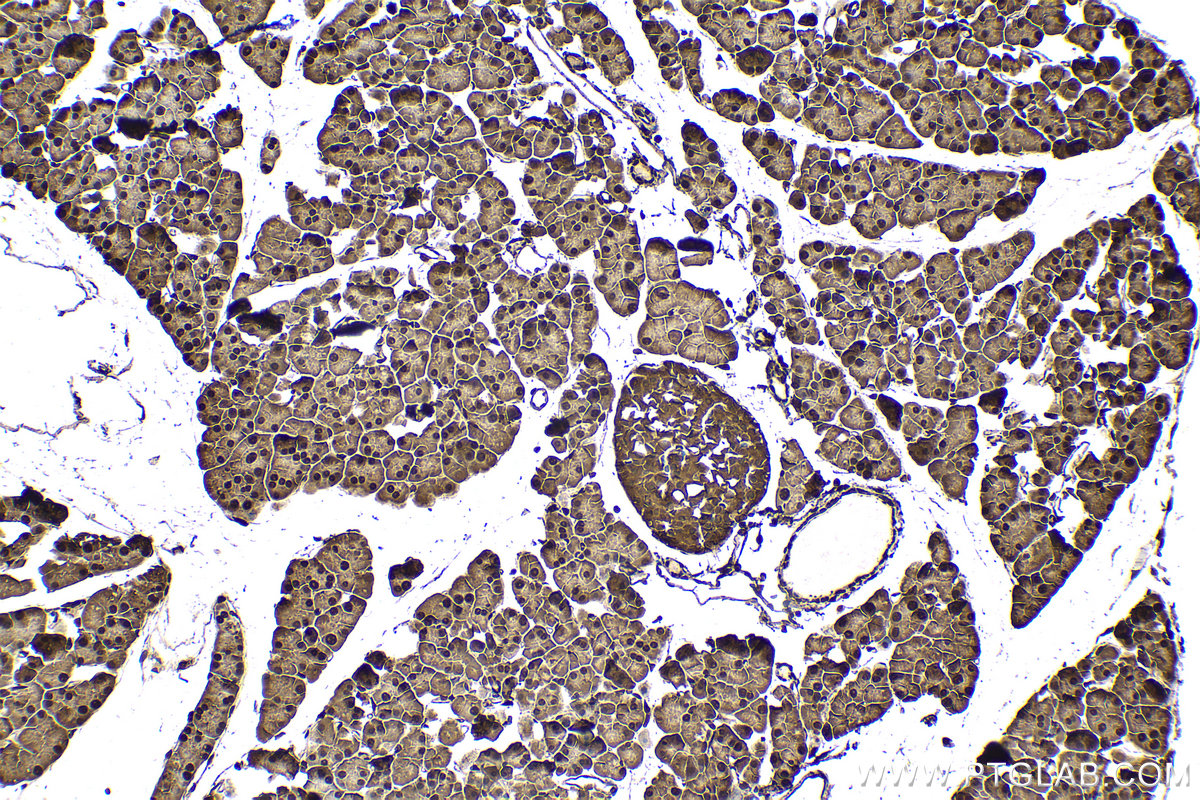

IHCeasy® UBB Ready-To-Use IHC Kit
UBB Ready-to-use reagent kit for IHC.
Reactivity
Human, Mouse, Rat
Sample Type
FFPE tissue
Cat no : KHC1518
Synonyms
FLJ25987, Polyubiquitin B, UBB, ubiquitin, ubiquitin B
Validation Data Gallery
Product Information
KHC1518 is a ready-to-use IHC kit for staining of UBB. The kit provides all reagents, from antigen retrieval to cover slip mounting, that require little to no diluting or handling prior to use. Simply apply the reagents to your sample slide according to the protocol and you're steps away from obtaining high-quality IHC data.
| Product name | IHCeasy UBB Ready-To-Use IHC Kit |
| Sample type | FFPE tissue |
| Assay type | Immunohistochemistry |
| Primary antibody type | Rabbit Recombinant |
| Secondary antibody type | Polymer-HRP-Goat anti-Rabbit |
| Reactivity | Human, Mouse, Rat |
Kit components
| Component | Size | Concentration |
|---|---|---|
| Antigen Retrieval Buffer | 100 mL | 50× |
| Washing Buffer | 100 mL ×2 | 20× |
| Blocking Buffer | 5 mL | RTU |
| Primary Antibody | 5 mL | RTU |
| Secondary Antibody | 5 mL | RTU |
| Chromogen Component A | 0.2 mL | RTU |
| Chromogen Component B | 4 mL | RTU |
| Signal Enhancer | 5 mL | RTU |
| Counter Staining Reagent | 5 mL | RTU |
| Mounting Media | 5 mL | RTU |
| Datasheet | 1 Copy | |
| Manual | 1 Copy |
Background Information
Ubiquitin B (UBB) is a member of ubiquitin family, one of the most conserved proteins known. Ubiquitin B is required for ATP-dependent, non-lysosomal intracellular protein degradation of abnormal proteins and normal proteins with a rapid turnover. Ubiquitin B is covalently bound to proteins to be degraded, and presumably labels these proteins for degradation. Ubiquitin also binds to histone H2A in actively transcribed regions but does not cause histone H2A degradation, suggesting that ubiquitin is also involved in regulation of gene expression. When polyubiquitin is free (unanchored-polyubiquitin), it also has distinct roles, such as in activation of protein kinases, and in signaling. This gene consists of three direct repeats of the ubiquitin coding sequence with no spacer sequence. Consequently, the protein is expressed as a polyubiquitin precursor with a final amino acid after the last repeat. Aberrant form of this protein has been noticed in patients with Alzheimer's and Down syndrome. Interestingly ubiquitin also becomes covalently bonded to many types of pathological inclusions which appear to be resistant to normal degradation.
Properties
| Storage Instructions | All the reagents are stored at 2-8°C. The kit is stable for 6 months from the date of receipt. |
| Synonyms | FLJ25987, Polyubiquitin B, UBB, ubiquitin, ubiquitin B |